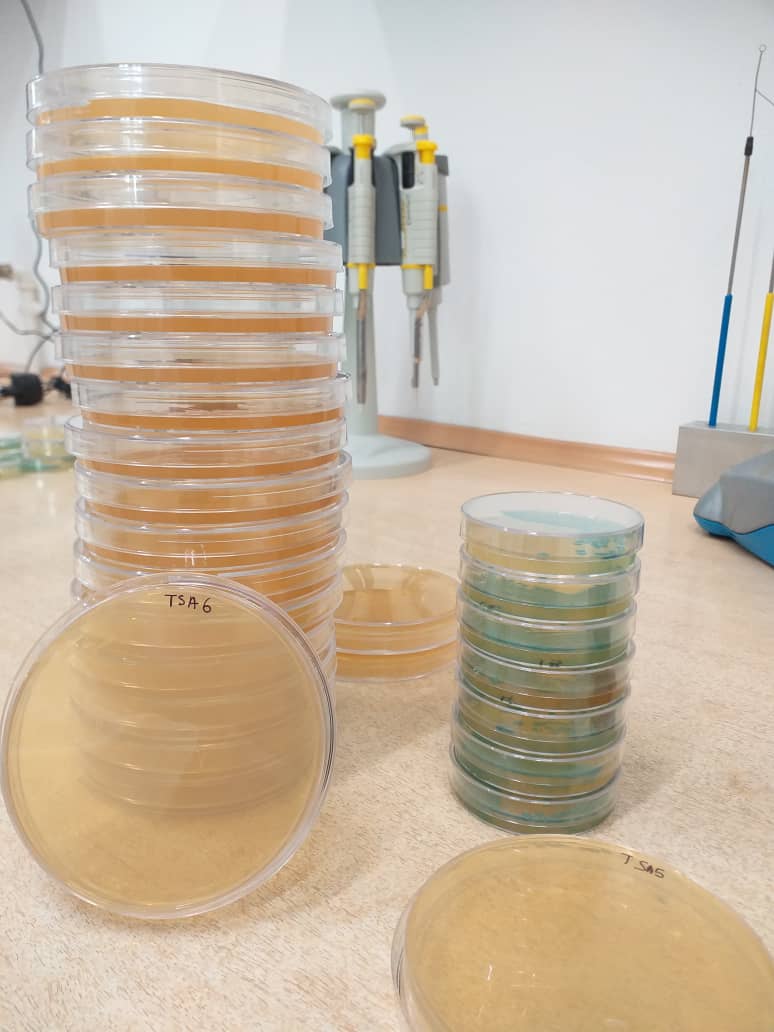

Wszystkie drogi prowadzą do Olsztyna - stażystki z zagranicy na Wydziale Nauki o Żywności
Na naszym Wydziale Nauki o Żywności Uniwersytetu Warmińsko-Mazurskiego w Olsztynie mamy przyjemność gościć dwie doktorantki z zagranicy – Somię Hallaci z Algierii oraz Chiarę Pisanę z Włoch. Obie realizują u nas swoje projekty badawcze w ramach staży naukowych.
Somia Hallaci pokonała 3000 km (to bardzo dużo), aby studiować właśnie na naszym wydziale. Pochodzi z Guelmy, miasta położonego w Algierii. Jest doktorantką mikrobiologii środowiskowej i sanitarnej na Uniwersytecie 8 Maja 1945 w Guelmie. W Olsztynie, na Wydziale Nauki o Żywności UWM, realizuje część swojego doktoratu, badając mikrobiologiczne ryzyko związane ze spożywaniem mięsa w Algierii.
– Wybrałam Uniwersytet Warmińsko-Mazurski, ponieważ jego profil naukowy doskonale wpisuje się w moje zainteresowania badawcze, a uczelnia cieszy się świetną reputacją w dziedzinie nauk o żywności. Wydział Nauki o Żywności oferuje nowoczesne laboratoria i doświadczoną kadrę, której prace są bliskie mojej specjalizacji. To idealne miejsce do rozwijania moich badań. – mówi Somia.
Olsztyn urzekł ją spokojem, zielenią i otwartością ludzi. – Jestem tu po raz drugi i bardzo doceniam spokojną atmosferę miasta, czystość, piękne otoczenie przyrody i przyjaznych mieszkańców. Szczególnie podobał mi się Wydział Nauki o Żywności, ponieważ panowała tam bardzo przyjazna atmosfera, a pracownicy byli niezwykle mili i pomocni. Jestem szczególnie wdzięczna za spotkanie z dr Arkadiuszem Zakrzewskim — był niezwykle miły, pomocny i inspirujący, za co jestem mu bardzo wdzięczna.
Podczas stażu Somia pracuje nad analizą próbek mięsa przywiezionych z Algierii. W laboratorium identyfikuje bakterie, by ocenić jakość i bezpieczeństwo produktów. Jak sama mówi, możliwość prowadzenia badań w tak dobrze wyposażonym miejscu i w przyjaznej atmosferze to dla niej ogromna motywacja.
Nasza druga stażystka – Chiara Pisana – pochodzi ze słonecznych Włoch i jest doktorantką biotechnologii ze specjalizacją w rolnictwie i żywności na Uniwersytecie w Katanii. Do Olsztyna przyjechała na trzymiesięczny pobyt badawczy w ramach prestiżowego programu CORE Organic Early Career Researchers Mobility Grant.
– Katedra Mikrobiologii Żywności, Technologii Mięsa i Chemii na Wydziale Nauki o Żywności była idealnym miejscem dla mojego projektu badawczego CORE Organic. Bogate doświadczenie w mikrobiologicznej analizie żywności, bezpieczeństwie żywności i analizie molekularnej bakterii kwasu mlekowego było kluczowe dla mojej pracy. Byłam przekonana, że UWM zapewni zaawansowane zaplecze badawcze i fachowy nadzór (prof. Wiolety Chajęckiej-Wierzchowskiej) niezbędne do osiągnięcia moich celów naukowych – mówi Chiara.
Podczas stażu Chiara pracuje nad projektem „Zrównoważone i innowacyjne systemy kontroli biologicznej poprawiające bezpieczeństwo serów świeżych dzięki bakteriofagom i postbiotykom”. W skrócie – rozwija pomysły na nowoczesne, ekologiczne opakowania, które mają zwiększyć bezpieczeństwo żywności i ograniczyć użycie plastiku.
– Najbardziej cenię możliwość prowadzenia badań, które łączą innowacje technologiczne z troską o środowisko. Praca w międzynarodowym zespole na UWM to dla mnie niezwykle rozwijające doświadczenie – mówi Chiara.
Cieszymy się, że nasz Wydział może wspierać rozwój nie tylko studentów z Polski, ale też młodych naukowców z całego świata.
Życzymy naszym stażystkom wielu naukowych sukcesów i pięknych wspomnień z czasu spędzonego na Wydziale Nauki o Żywności UWM!
English version
At the Faculty of Food Science at the University of Warmia and Mazury in Olsztyn, we have the pleasure of hosting two doctoral students from abroad – Somia Hallaci from Algeria and Chiara Pisana from Italy. Both are conducting their research projects here as part of scientific internships.
Somia Hallaci traveled 3,000 km (quite a distance) to study at our faculty. She comes from Guelma, a city in Algeria, and is a PhD student in environmental and sanitary Microbiology at the University of 08 May 1945 in Guelma. At the University of Warmia and Mazury in Olsztyn, she is carrying out part of her doctoral research, focusing on the microbiological risks associated with the consumption of meat in Algeria.
- I chose the University of Warmia and Mazury because it's an area directly related to my research interests and has a strong reputation in food science. The Faculty of Food Science offers modern equipment and experienced Professors whose work aligns with my field, particularly in microbial risk assessment and meat quality. This makes it the ideal environment in which to develop my research. – says Somia.
Olsztyn has captivated her with its calm atmosphere, greenery, and the openness of its residents. – This is my second time here and I really appreciated the city's calm atmosphere, cleanliness, beautiful natural surroundings and friendly people. The Faculty of Food Science was a particular highlight for me as I found it to be a very welcoming and supportive environment with extremely kind and helpful staff. I am especially grateful to have met Dr Arkadiusz — he has been incredibly kind, supportive and inspiring, for which
I am very grateful.
During her stay, Somia is analyzing meat samples brought from Algeria. In the laboratory, she identifies bacteria to assess product quality and safety. As she says, having the opportunity to conduct research in such a well-equipped environment and friendly atmosphere is a great motivation for her.
Our second intern – Chiara Pisana – comes from sunny Italy and is a PhD student in Biotechnology with a specialization in Agri-food at the University of Catania. She came to Olsztyn for a three-month research stay as part of the prestigious program CORE Organic Early Career Researchers Mobility Grant.
- I chose the Faculty of Food Science because the Department of Food Microbiology, Meat Technology and Chemistry was the ideal host for my CORE Organic research project. Their strong expertise in microbiological food analysis, food safety, and molecular analysis of Lactic Acid Bacteria was crucial for my work. I was confident that UWM would provide the advanced research facilities and the expert supervision (from prof. Wioleta Chajęcka-Wierzchowska) needed to achieve my scientific goals.
During her internship, Chiara is working on the project „Sustainable and innovative biocontrol systems to improve fresh cheeses safety through bacteriophages and postbiotics”. She is developing innovative, eco-friendly packaging solutions designed to improve food safety while reducing plastic use.
- What I enjoy most is the ability to conduct research that is directly aligned with global sustainability goals. This project allows me to combine technological innovation with environmental responsibility, aiming to revolutionize the food packaging sector. The chance to collaborate with an international team at UWM is an invaluable opportunity that significantly enhances my professional and academic growth. – says Chiara.
We are proud that our Faculty can support the development not only of students from Poland but also of young scientists from around the world.
We wish our interns many scientific achievements and wonderful memories from their time at the Faculty of Food Science, University of Warmia and Mazury in Olsztyn!